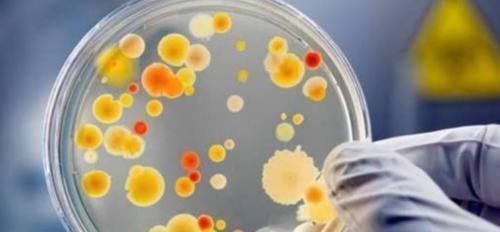
人类知道的东西太少了科学家又发现30个新物种,却只是冰山一角

人类知道的东西太少了科学家又发现30个新物种,却只是冰山一角
其实在宇宙中,地球是非常不起眼的,不过,因为地球上孕育出了生命,也让地球成为宇宙中最特别的存在。那么,地球上究竟有多少种生物呢?
文章插图
地球上的物种有多少?
根据研究,科学家们认为,地球在42.8亿年之前,就已经诞生生命了,自从人类出现后,特别是人类进入到文明社会之后,人类对于地球上的生物了解,就开始逐渐展开了,截止到目前为止,地球上已知的物种数量,大约在174万种左右。
研究者表示,其中昆虫的数量就超过90万种,剩下的是40多万种的植物,近20余万种的动物,以及各类微生物、原核和原生生物。
看到这里,大家是不是会觉得地球上的生物种类,已经非常多了,事实上,这不过是地球生物的冰山一角。
文章插图
在2017年,一支来自于美国著名的公立研究型大学——印第安纳大学的科学家团队,在全球范围内,设置了3.5万个样本采集点,发现每1克的土壤中,竟然包含着上万种的生物。最终,通过演算,认为地球上的物种数量,大约在1万亿左右。
这意味着什么呢?意味着人类对于地球生物的了解,仅有0.001左右,地球上仍然有99.999%的生物是未知的,而在探索它们的道路上,显然,人类是很难将全部的物种都调查清楚的。
文章插图
科学家又发现30个新物种!
根据资料显示,一个国际海洋科学家小组,在厄瓜多尔加拉帕戈斯国家公园周围的深海中,发现了30种新的无脊椎动物。
这些新物种的生命形式都非常的原始,它们的祖先也应该是地球上最古老的居民,它们生活在距离海面3400米以下的地方,主要是珊瑚和海绵。
研究者表示,虽然厄瓜多尔的海洋捕捞现象非常普遍,但是加拉帕格斯群岛周边的海域生态系统,却是非常原始的,所以,才会找到这么多新的物种。
这个发现也意味着,在地球的深海之中,的确隐藏着很多未知的生物,人类如果想要更好的了解地球,了解地球生命,那么深海势必是最值得探索的地方之一。
文章插图
未知物种都在哪里?
未知的物种都隐藏在哪里呢?研究认为,这些未知的物种中,微生物的数量应该是非常惊人的,此外还有一些非常原始的古老生命形式,它们大多隐藏在深海、雨林深处等,因为这些地方人类尚未涉足,所以想要搞清楚它们究竟在哪里,并不容易。
同时,科学家也认为,在这些未知的神秘地带,因为物种是完全自然演化的,所以,或许在物种的演化过程中,也会不断发生变异的情况,导致新物种的出现。
文章插图
【 人类知道的东西太少了科学家又发现30个新物种,却只是冰山一角】这也就意味着,未知的物种数量,或许是不断增加的,因为人类对于地球了解太少了,根本就没有办法将它们全部找到。大家觉得,未来人类有机会彻底搞清楚地球上全部的物种分布吗?欢迎留言,说说你的看法!
推荐阅读
- 交付 沉了!这艘刚交付的“新”船只跑了3次!船东将遭起诉和高额索赔
- 理论 黑洞是什么,它又是怎样形成的,一起来认识下吧
- 速度 宇宙中比光速更快的四种“速度”,你都知道几个
- 氢能冶金 碳中和正在进行时,炼铁氢还原替代碳还原的新时代已至!
- 约瑟夫·拜登 非要跟中国较量?美国疯狂印钞6万亿,结果搬起石头砸自己的脚
- 初入职场的我们 《初入职场的我们》郑茹心为什么会离开?
- 这就是街舞3 娱乐圈中的团宠,张艺兴凭借偶像特质,征服全网观众,获赞无数
- b《心动的信号4》官宣阵容,baby加盟,郭麒麟、宋祖儿惊喜现身
- 向往的生活5 李诞拥抱张艺兴,后者一脸地抗拒,但张艺兴和杨紫却可以亲密互动
- 心动的信号4 嘉宾阵容大洗牌!baby、宋祖儿加盟,张翰、杨超越退出
